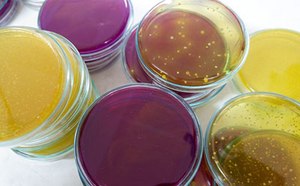

Learning Hubs for Life Science Research
Explore essential analytical chemistry techniques and tools across chromatography, spectroscopy, and sample preparation for reliable lab workflows.
Discover the different aspects of cell culture! Learn more about how in vitro cell culture models can be used to study cell behavior, function, development, and differentiation.
Explore our wide range of innovative products and enabling technologies for end-to-end solutions in your chemical synthesis workflows and applications.
We are committed to advancing food and beverage safety and quality throughout the world. Our scientific and regulatory experts have developed an extensive library of articles and protocols.
Explore technical resources and molecular tools for cloning, expression, nucleic acid purification, PCR, gene editing, and NGS applications.
Microbiological testing is used in pharmaceutical, cosmetic, municipal water, and food and beverage industries to provide safe products for consumption.
To continue reading please sign in or create an account.
Don't Have An Account?